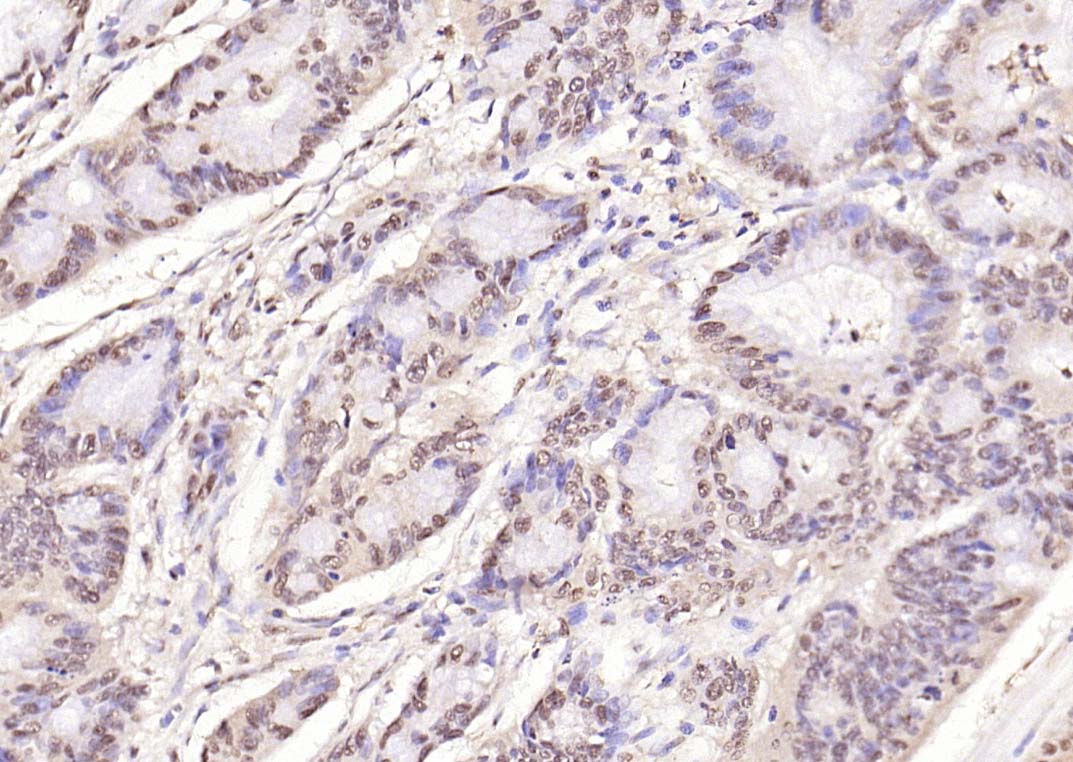
产品细节图片7

相关产品推荐更多 >

RBM6 Rabbit pAb(bs-19775R)-50ul/100ul/200ul
¥1180
RSPRY1 Rabbit pAb(bs-18879R)-50ul/100ul/200ul
¥1180
2-Hydroxyisobutyryl-Histone H3 (Lys14) Recombinant Rabbit mAb(bsm-60209R)-50ul/100ul/25ul
¥800
Nebulette Rabbit pAb, HRP conjugated(bs-9468R-HRP)-100ul
¥2980
THEMIS Rabbit pAb, HRP conjugated(bs-12329R-HRP)-100ul
¥2980
万千商家帮你免费找货
0 人在求购买到急需产品
- 详细信息
- 文献和实验
- 技术资料
- 应用范围:
产品信息以Bioss网站为准
- 规格:
50ul/100ul/200ul
| 规格: | 50ul | 产品价格: | ¥1180.0 |
|---|---|---|---|
| 规格: | 100ul | 产品价格: | ¥1980.0 |
| 规格: | 200ul | 产品价格: | ¥2800.0 |
| 产品编号 | bs-5513R |
| 英文名称 | phospho-NFKB1 (Ser893) Rabbit pAb |
| 中文名称 | 磷酸化细胞核因子p50/k基因结合核因子抗体 |
| 英文别名 | NFKB1_HUMAN; Nuclear factor NF-kappa-B p105 subunit; DNA-binding factor KBF1; EBP-1; Nuclear factor of kappa light polypeptide gene enhancer in B-cells 1; Nuclear factor NF-kappa-B p50 subunit; NFkB p105/p50; NFkB p105/p50; nuclear factor kappa B subunit 1; NF-kB; CVID12; NF-kB1; NFKB-p50; NFkappaB; NF-kappaB; NFKB-p105; NF-kappa-B1; NF-kappabeta; |
| 产品应用 | IHC-P=1:100-500, IHC-F=1:100-500, IF=1:100-500, Flow-Cyt=1μg/Test Not yet tested in other applications. |
| 交叉反应 | Human, Mouse (Cow, Horse, Rabbit) |
| 抗体来源 | Rabbit |
| 免疫原 | KLH conjugated Synthesised phosphopeptide derived from human NF KappaB p105 around the phosphorylation site of Ser893 |
| 亚型 | IgG |
| 性状 | Liquid |
| 纯化方法 | affinity purified by Protein A |
| 克隆类型 | Polyclonal |
| 理论分子量 | 105 kDa |
| 浓度 | 1mg/ml |
| 储存液 | 0.01M TBS (pH7.4) with 1% BSA, 0.02% Proclin300 and 50% Glycerol. |
| 研究领域 | Cancer > Cell Death > Apoptosis > Apoptosis Markers > NFkB > p50 Cancer > Signal transduction > Nuclear signaling > NFkB pathway Cell Biology > Apoptosis > Intracellular > NFkB > p50 Epigenetics and Nuclear Signaling > Nuclear Signaling Pathways > NFkB pathway Epigenetics and Nuclear Signaling > Transcription > Transcription Factors Immunology > Innate Immunity > Macrophage / Inflamm. Signal Transduction > Signaling Pathway > Nuclear Signaling > NFkB Pathway |
| 亚基 | Component of the NF-kappa-B p65-p50 complex. Component of the NF-kappa-B p65-p50 complex. Homodimer; component of the NF-kappa-B p50-p50 complex. Component of the NF-kappa-B p105-p50 complex. Component of the NF-kappa-B p50-c-Rel complex. Component of a complex consisting of the NF-kappa-B p50-p50 homodimer and BCL3. Also interacts with MAP3K8. NF-kappa-B p50 subunit interacts with NCOA3 coactivator, which may coactivate NF-kappa-B dependent expression via its histone acetyltransferase activity. Interacts with DSIPI; this interaction prevents nuclear translocation and DNA-binding. Interacts with SPAG9 and UNC5CL. NFKB1/p105 interacts with CFLAR; the interaction inhibits p105 processing into p50. NFKB1/p105 forms a ternary complex with MAP3K8 and TNIP2. Interacts with GSK3B; the interaction prevents processing of p105 to p50. NFKB1/p50 interacts with NFKBIE. NFKB1/p50 interacts with NFKBIZ. Nuclear factor NF-kappa-B p50 subunit interacts with NFKBID. Directly interacts with MEN1. Interacts with HIF1AN. |
| 亚细胞定位 | Nucleus. Cytoplasm. Note=Nuclear, but also found in the cytoplasm in an inactive form complexed to an inhibitor (I-kappa-B). |
| 翻译后修饰 | While translation occurs, the particular unfolded structure after the GRR repeat promotes the generation of p50 making it an acceptable substrate for the proteasome. This process is known as cotranslational processing. The processed form is active and the unprocessed form acts as an inhibitor (I kappa B-like), being able to form cytosolic complexes with NF-kappa B, trapping it in the cytoplasm. Complete folding of the region downstream of the GRR repeat precludes processing.
Phosphorylation at 'Ser-903' and 'Ser-907' primes p105 for proteolytic processing in response to TNF-alpha stimulation. Phosphorylation at 'Ser-927' and 'Ser-932' are required for BTRC/BTRCP-mediated proteolysis. Polyubiquitination seems to allow p105 processing. S-nitrosylation of Cys-61 affects DNA binding. The covalent modification of cysteine by 15-deoxy-Delta12,14-prostaglandin-J2 is autocatalytic and reversible. It may occur as an alternative to other cysteine modifications, such as S-nitrosylation and S-palmitoylation. |
| 相似性 | Contains 7 ANK repeats.
Contains 1 death domain. Contains 1 RHD (Rel-like) domain. |
| 功能 | NF-kappa-B is a pleiotropic transcription factor present in almost all cell types and is the endpoint of a series of signal transduction events that are initiated by a vast array of stimuli related to many biological processes such as inflammation, immunity, differentiation, cell growth, tumorigenesis and apoptosis. NF-kappa-B is a homo- or heterodimeric complex formed by the Rel-like domain-containing proteins RELA/p65, RELB, NFKB1/p105, NFKB1/p50, REL and NFKB2/p52 and the heterodimeric p65-p50 complex appears to be most abundant one. The dimers bind at kappa-B sites in the DNA of their target genes and the individual dimers have distinct preferences for different kappa-B sites that they can bind with distinguishable affinity and specificity. Different dimer combinations act as transcriptional activators or repressors, respectively. NF-kappa-B is controlled by various mechanisms of post-translational modification and subcellular compartmentalization as well as by interactions with other cofactors or corepressors. NF-kappa-B complexes are held in the cytoplasm in an inactive state complexed with members of the NF-kappa-B inhibitor (I-kappa-B) family. In a conventional activation pathway, I-kappa-B is phosphorylated by I-kappa-B kinases (IKKs) in response to different activators, subsequently degraded thus liberating the active NF-kappa-B complex which translocates to the nucleus. NF-kappa-B heterodimeric p65-p50 and RelB-p50 complexes are transcriptional activators. The NF-kappa-B p50-p50 homodimer is a transcriptional repressor, but can act as a transcriptional activator when associated with BCL3. NFKB1 appears to have dual functions such as cytoplasmic retention of attached NF-kappa-B proteins by p105 and generation of p50 by a cotranslational processing. The proteasome-mediated process ensures the production of both p50 and p105 and preserves their independent function, although processing of NFKB1/p105 also appears to occur post-translationally. p50 binds to the kappa-B consensus sequence 5'-GGRNNYYCC-3', located in the enhancer region of genes involved in immune response and acute phase reactions. In a complex with MAP3K8, NFKB1/p105 represses MAP3K8-induced MAPK signaling; active MAP3K8 is released by proteasome-dependent degradation of NFKB1/p105. |
| 保存条件 | Shipped at 4℃. Store at -20℃ for one year. Avoid repeated freeze/thaw cycles. |
| 注意事项 | This product as supplied is intended for research use only, not for use in human, therapeutic or diagnostic applications. |
| 背景资料 | This gene encodes a 105 kD protein which can undergo cotranslational processing by the 26S proteasome to produce a 50 kD protein. The 105 kD protein is a Rel protein-specific transcription inhibitor and the 50 kD protein is a DNA binding subunit of the NF-kappa-B (NFKB) protein complex. NFKB is a transcription regulator that is activated by various intra- and extra-cellular stimuli such as cytokines, oxidant-free radicals, ultraviolet irradiation, and bacterial or viral products. Activated NFKB translocates into the nucleus and stimulates the expression of genes involved in a wide variety of biological functions. Inappropriate activation of NFKB has been associated with a number of inflammatory diseases while persistent inhibition of NFKB leads to inappropriate immune cell development or delayed cell growth. Two transcript variants encoding different isoforms have been found for this gene. [provided by RefSeq, Sep 2009]. |
| 应用 | 推荐稀释比例 |
| {IHC-P} | {1:100-500} |
| {IHC-F} | {1:100-500} |
| {IF} | {1:100-500} |
| {Flow-Cyt} | {1μg/Test} |


Primary Antibody (green line): Rabbit Anti-Phospho-NFKB1 (Ser893)antibody (bs-5513R),Dilution: 1μg /10^6 cells;
Isotype Control Antibody (orange line): Rabbit IgG .
Secondary Antibody (white blue line): Goat anti-rabbit IgG-FITC,Dilution: 1μg /test.

风险提示:丁香通仅作为第三方平台,为商家信息发布提供平台空间。用户咨询产品时请注意保护个人信息及财产安全,合理判断,谨慎选购商品,商家和用户对交易行为负责。对于医疗器械类产品,请先查证核实企业经营资质和医疗器械产品注册证情况。
文献和实验:使用 Anti-phospho-Akt (Ser473) Rabbit mAb 对石蜡包埋的人乳腺癌组织进行免疫组织化学分析。(图 A)使用免疫组化试剂盒M&R HRP/DAB Detection IHC Kit,抗体 1:100 稀释;(图 B) 采用普通免疫组化试剂盒,抗体 1:25 稀释。 图 6 免疫组化实验检测 Erk1/2 表达 注:使用 Anti-Erk1/2 Mouse mAb与p44/42 MAPK (Erk1/2)Rabbit mAb 对正常小鼠心脏组织进行免疫
at 10, 25, and 50 μM). At 24 h post-treatment, celllysates were obtained; SDS-PAGE and Western blotting were performed as described in Section 3, Methods. AR-A014418dose-dependent decreases of phospho-β-catenin (Ser33/37) and phospho-glycogen synthase
(Ser473)(193H12)Rabbit mAb,1:300,稀释,二抗是驴抗兔,1:2000,我是实验室的新手,刚呆俩月,受 此挫折,一头雾水,请过来人或者有经验的同学帮忙解答怎样解决,非常感谢! 碧峤 pAkt有两个位点,Ser473和Thr308,其中Ser473相对容易显色。如果显色失败,可能的原因:1 上样量过少,我们一般都是30μg;2 一抗孵育时间过短,我们一般24h~48h;3 一抗是否工作有待排除 米宝
技术资料暂无技术资料 索取技术资料






